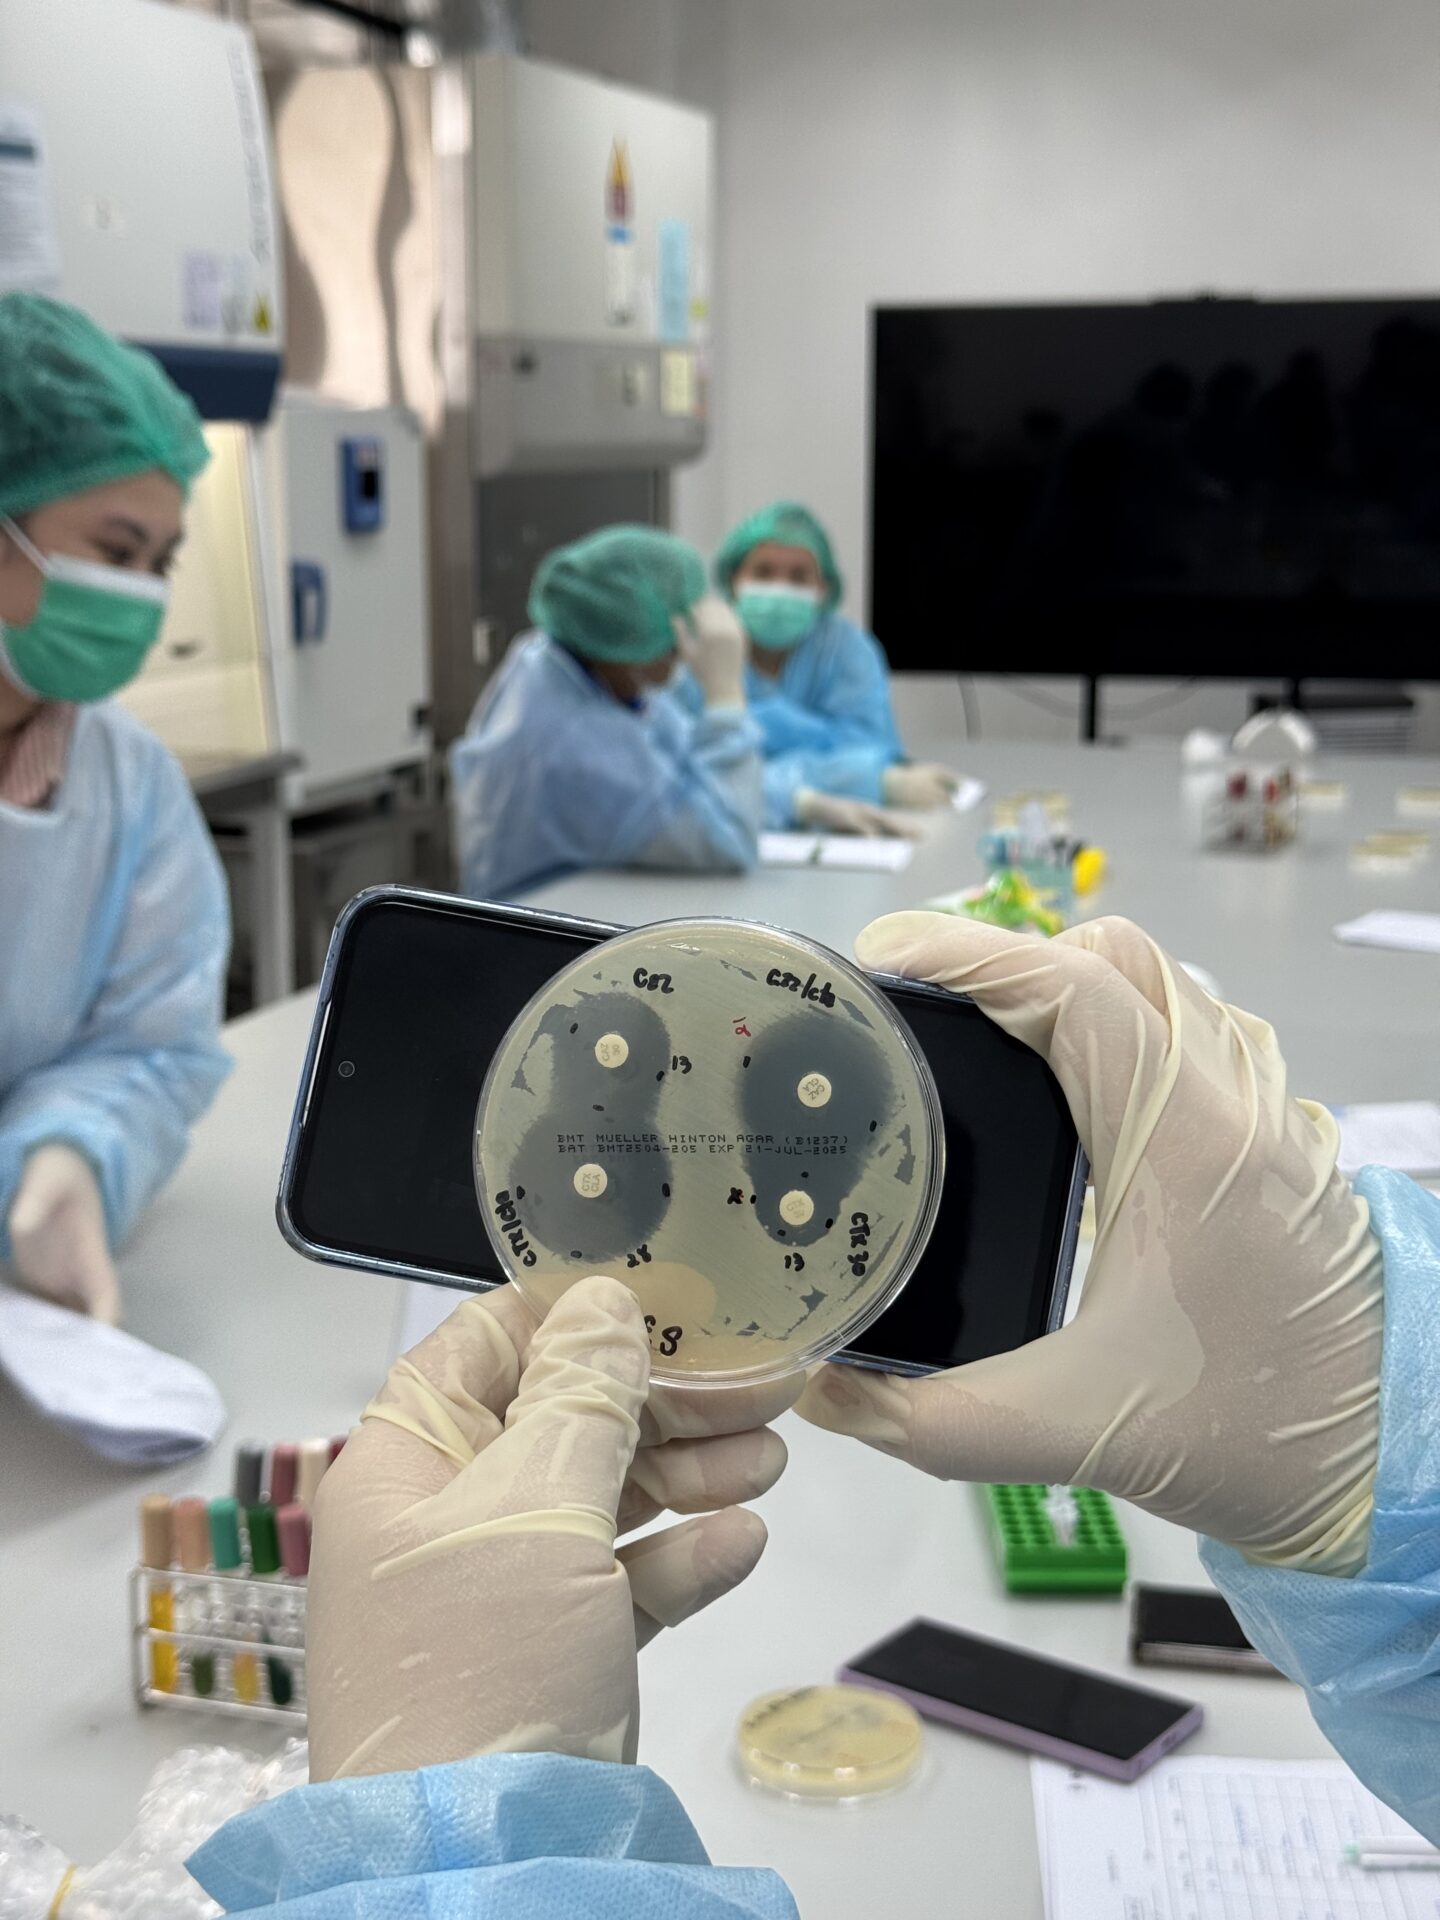

ปัญหาสารมลพิษอุบัติใหม่ปนเปื้อนในแหล่งน้ำเป็นโจทย์ท้าทายระดับชาติต้องหาแนวทางควบคุมอย่างเร่งด่วนเพื่อลดผลกระทบทางสิ่งแวดล้อมและสุขภาพของคนไทย เมื่อสถานการณ์ปนเปื้อนสารมลพิษอุบัติใหม่มีแนวโน้มเพิ่มมากขึ้นในประเทศไทย โดยเฉพาะลุ่มแม่น้ำเจ้าพระยา ลุ่มน้ำท่าจีน และชายฝั่งทะเลตะวันออกอย่าง จ.ชลบุรี การเตรียมความพร้อมรับมือและการควบคุมสารมลพิษอุบัติใหม่อย่างจริงจังเป็นเรื่องสำคัญ
เหตุนี้ กรมควบคุมมลพิษ ร่วมกับสำนักงานพัฒนาวิทยาศาสตร์และเทคโนโลยีแห่งชาติ กรมชลประทาน และจุฬาลงกรณ์มหาวิทยาลัย ลงนามบันทึกข้อตกลงความร่วมมือ (MOU) “การยกระดับขีดความสามารถด้านการจัดการคุณภาพน้ำและการปนเปื้อนในแหล่งน้ำของประเทศไทย” ที่กรมชลประทาน เมื่อวันก่อน มุ่งส่งเสริมการศึกษา วิจัย และพัฒนาเทคโนโลยีด้านการจัดการคุณภาพน้ำและการควบคุมสารมลพิษอุบัติใหม่ในแหล่งน้ำของประเทศไทยผ่านการบูรณาการองค์ความรู้ การพัฒนาบุคลากร การถ่ายทอดเทคโนโลยีและสร้างเครือข่ายความร่วมมือทั้งในและต่างประเทศ

นางสาวปรีญาพร สุวรรณเกษ อธิบดีกรมควบคุมมลพิษ กล่าวว่า ปัญหาด้านคุณภาพน้ำและการปนเปื้อนในแหล่งน้ำ ไม่ว่าจะเกิดขึ้นในประเทศไทยหรือจากพื้นที่โดยรอบที่เข้าสู่ประเทศไทย ล้วนมีความรุนแรง ซับซ้อน และแพร่กระจายสู่สิ่งแวดล้อมอย่างรวดเร็ว การปนเปื้อนของโลหะหนักหรือสารมลพิษอุบัติใหม่เหล่านี้จำเป็นต้องมีการศึกษาวิจัยและพัฒนาเทคโนโลยีสำหรับการตรวจวัด วิเคราะห์ ติดตาม และกำจัด เพื่อให้เกิดการเรียนรู้และการเฝ้าระวังที่เท่าทันกับสถานการณ์ที่เกิดขึ้นทั้งในระดับประเทศและระดับสากล คพ.มีบทบาทสำคัญติดตามตรวจสอบคุณภาพน้ำของประเทศ MOU 4 หน่วยงาน เป็นก้าวสำคัญในการบูรณาการร่วมกัน ครอบคลุมทั้งด้านการศึกษา การวิจัยและพัฒนา รวมถึงการเผยแพร่องค์ความรู้ด้านการแก้ไขปัญหาและการจัดการคุณภาพน้ำ ตลอดจนการปนเปื้อนในแหล่งน้ำ เพื่อยกระดับคุณภาพสิ่งแวดล้อมของประเทศและประชาชนได้รับสิ่งแวดล้อมที่ดี

ดร.ชานัน ติรณะรัต ผอ.สำนักจัดการคุณภาพน้ำ คพ. กล่าวว่า มลพิษอุบัติใหม่แตกต่างจากมลพิษทั่วไปที่คนส่วนใหญ่รู้จักดี อย่างน้ำเสีย กลิ่นเหม็นรบกวน ฝุ่นละอองขนาดเล็ก หรือ PM2.5 ซึ่งมีการกำหนดมาตรฐานค่าความเข้มข้นในสิ่งแวดล้อมและระบบบำบัดจัดการสารเหล่านี้อยู่แล้วทั้งในระดับชุมชน สถานประกอบการ หรือโรงงานอุตสาหกรรม แต่มลพิษอุบัติใหม่แฝงเข้ามาในผลิตภัณฑ์ที่เราใช้โดยไม่รู้ตัว เช่น ยาปฏิชีวนะ เครื่องสำอาง ยาแก้ปวด สารเคลือบกระทะ หรือแม้แต่สารไมโครพลาสติกที่แตกตัวไปจากเสื้อผ้าหรือผลิตภัณฑ์ที่ใช้จำนวนมากในปัจจุบัน ปัจจุบันเริ่มส่งผลกระทบต่อสิ่งแวดล้อมและสุขภาพจากการปนเปื้อนมลพิษเหล่านี้ในสิ่งแวดล้อม ซึ่งในอดีตไม่เคยตรวจพบ ทาง คพ.จึงติดตามและตรวจสอบมลพิษที่เกิดขึ้นใหม่
“ สารมลพิษอุบัติใหม่ที่เกิดขึ้นในสิ่งแวดล้อม ประเทศไทยยังไม่มีค่าแนะนำที่ควรจะมีในสิ่งแวดล้อม ปริมาณที่เหมาะสม ขณะที่การตรวจจับหรือตรวจวัดต้องใช้เทคโนโลยีชั้นสูง ใช้ผู้เชี่ยวชาญดู รวมถึงจะมีแนวทางจัดการปนเปื้อนและไม่ปล่อยออกสู่สิ่งแวดล้อมอย่างไร ถือเป็น 3 ประเด็นหลักที่ท้าทายและไทยต้องเตรียมมือ ประเทศไทยต้องตื่นตัว เพราะสารกลุ่มนี้อยู่นอกระบบควบคุม ปัจจุบันไม่มีค่ามาตรฐาน การเฝ้าระวังยังน้อย ไม่มีการกำหนดกฎหมายเฉพาะ มีความกังวลเข้าสู่สิ่งแวดล้อม สู่ระบบห่วงโซ่อาหาร อีกทั้งการใช้ยาปฏิชีวนะในคน พืช สัตว์ มากขึ้น การหลุดลอดของมลพิษอุบัติใหม่จะส่งผลเกิดเชื้อดื้อยา เสี่ยงต่อระบบสาธารณสุขอีกด้วย “ ดร.ชานัน กล่าว

สำหรับสถานการณ์มลพิษอุบัติใหม่ในปัจจุบัน ผอ.สำนักจัดการคุณภาพน้ำ กล่าวว่า คพ.ดำเนินการติดตามตรวจสอบสารมลพิษอุบัติใหม่อย่างต่อเนื่องทั่วประเทศ โดยเฉพาะในลุ่มน้ำเจ้าพระยา ลุ่มแม่น้ำท่าจีนตอนล่าง เหตุที่โฟกัสพื้นที่นี้เพราะมีความหนาแน่นของประชากรสูง มีแหล่งกำเนิดมลพิษหลากหลาย ทั้งภาคเกษตร ชุมชน อุตสาหกรรม และการพาณิชย์ พบการปนเปื้อนแบคทีเรียกลุ่มอีโคไลจำนวนมาก บ่งชี้ว่าหลุดลอดมาจากโรงพยาบาล ฟาร์มสัตว์ และชุมชน การเฝ้าระวังยังเน้นไมโครพลาสติกชายฝั่ง มีการตรวจไมโครพลาสติกทั้งในน้ำทะเลและตะกอนบริเวณปากแม่น้ำ เช่น บางปะกง อ่างศิลา บางแสน ที่มีกิจกรรมบนบกปนเปื้อนในทะเล รวมถึงเฝ้าระวังพื้นที่เพาะเลี้ยงสัตว์น้ำ อาจกระทบต่อผู้บริโภค สำหรับพื้นที่อื่นๆ ยังมีความเสี่ยงน้อย แต่ต้องติดตามเฝ้าระวังต่อเนื่อง รวมถึงแหล่งน้ำที่ใช้ผลิตน้ำประปาด้วย
ดร.ชานันย้ำปัญหาคุณภาพน้ำและการปนเปื้อนในแหล่งน้ำจากมลพิษใหม่จะส่งผลกระทบต่อสิ่งแวดล้อม ด้านสุขภาพของประชาชนก็น่าห่วง ระบบบำบัดน้ำเสียทั่วไป ระบบบำบัดน้ำเสียโรงพยาบาลจัดการไม่ได้จะปนเปื้อน หากปนเปื้อนในแหล่งน้ำที่ผลิตน้ำประปา ซึ่งระบบปัจจุบันบำบัดได้ไม่เพียงพอ ต้องจัดทำระบบพิเศษ ซับซ้อนมากขึ้น ใช้เทคโนโลยีมากขึ้น หากปนเปื้อนน้ำประปาจะส่งผลกระทบการพัฒนาเศรษฐกิจของประเทศ
ภัยมลพิษอุบัติใหม่ต้องมีแนวทางการรับมือ ผอ.สำนักจัดการคุณภาพน้ำ กล่าวว่า ประเทศไทยรวมเรื่องมลพิษอุบัติใหม่ไว้ในแผนแม่บทการจัดการทรัพยากรน้ำ 20 ปี ในมิติคุณภาพน้ำที่เหมาะสมต่อการใข้ประโยชน์ มลพิษอุบัติใหม่เป็นเรื่องใหม่ ต้องดำเนินการอย่างเร่งด่วน รวมถึงบรรจุไว้ในโรดแมฟขยะพลาสติกแห่งชาติ ปี 2561-2573 ซึ่งจะมีการจัดการขยะอย่างเป็นระบบ ลดปริมาณขยะพลาสติกลงสู่ทะเล ส่งเสริมการรีไซเคิลครบวงจร โดยกำหนดแนวทาง ค่าแนะนำ และเกณฑ์การเฝ้าระวังสำหรับสารบางประเภท เช่น ไมโครพลาสติก ยาปฏิชีวนะ ซึ่งจะพัฒนาไปสู่กฎหมายในอนาคต
สำหรับ MOU ฉบับนี้เป็นจุดเริ่มต้นรวมพลังแก้ปัญหามลพิษอุบัติใหม่ ดร.ชานัน กล่าวว่า MOU มีกรอบระยะเวลา 5 ปี (2568-2573) เมื่อการศึกษาวิจัยเสร็จเรียบร้อย จะมีการกำหนดค่ามาตรฐาน วิธีการ เทคนิคตรวจวัด เทคนิคการจัดการ ด้าน สวทช.จะคิดค้นพัฒนาเครื่องมือตรวจวัดคุณภาพสิ่งแวดล้อมอย่างรวดเร็วและเทียบเท่ามาตรฐานต่างประเทศ รวมถึงหาวิธีการที่ประหยัด แม่นยำ เข้ามาช่วย ส่วนจุฬาฯ เน้นงานวิจัยคิดค้นเทคโนโลยีและหาความสำคัญระหว่างสารมลพิษกับสิ่งแวดล้อม อีกทั้งมีเครือข่ายทางวิชาการสนับสนุน ภายใต้หน่วยงานเดียวทำงานไม่ได้ ภาคประชาชน ภาคเอกชนต้องเข้ามามีบทบาทและมีส่วนร่วม ต้องเตรียมความพร้อมผ่านงานวิจัยเพื่อให้เท่าทันความเสี่ยงที่เกิดขึ้น

ด้าน นายสุริยพล นุชอนงค์ อธิบดีกรมชลประทาน กล่าวว่า กรมชลประทานมีหน้าที่ในด้านการพัฒนาแหล่งน้ำและการบริหารจัดการน้ำแบบบูรณาการ ความร่วมมือนี้จะช่วยส่งเสริมให้มีการพัฒนามาตรการเชิงป้องกัน แก้ไข การออกมาตรฐานคุณภาพน้ำ เพื่อนำไปสู่แนวปฏิบัติด้านการตรวจวัด ติดตาม และประเมินผลคุณภาพน้ำของแม่น้ำและแหล่งน้ำทั้งระบบตามหลักวิชาการ เพื่อให้สามารถตอบสนองต่อปัญหาระดับพื้นที่อย่างเหมาะสม สอดคล้องกับบริบทของประเทศไทย ที่สำคัญคือเปิดโอกาสให้ประชาชนผู้ได้รับผลกระทบได้มีส่วนร่วมอย่างแท้จริง ถือเป็นอีกหนึ่งภารกิจสำคัญที่จะช่วยให้การจัดการทรัพยากรน้ำของประเทศมีประสิทธิภาพและยั่งยืน

ข่าวที่เกี่ยวข้อง
เปิดผลตรวจสารปนเปื้อนแม่น้ำกก-สาย-รวก-โขง สารหนูยังเกินมาตรฐานหลายจุด
กรมควบคุมมลพิษ(คพ.)รายงานผลการตรวจคุณภาพน้ำของแม่น้ำกก แม่น้ำสาย แม่น้ำรวกและโขงครั้งที่ 18 ซึ่งเก็บตัวอย่างน้ำระหว่างวันที่ 27 เมษายน – 1 พฤษภาคม 2569 พบว่า ภาพรวมค่าโลหะหนักส่วนใหญ่
คพ. พร้อมรับการตรวจสอบทุจริต แต่ชี้ผลสำรวจ กกร. เป็นข้อมูลเชิงการรับรู้ (Perception) และข้อมูลไม่รอบด้าน ไม่ควรใช้ชี้เฉพาะหน่วยงานหรือสะท้อนภาพรวมประเทศ
วันนี้ (25 พฤษภาคม 2569) ดร.สุรินทร์ วรกิจธำรง อธิบดีกรมควบคุมมลพิษ แถลงผลการพิจารณาเอกสารงานวิจัยการสำรวจความคิดเห็นภาคเอกชนของคณะกรรมการร่วมภาคเอกชน 3 สถาบัน (กกร.) กรณีระบุว่า กรมควบคุมมลพิษ (คพ.)
7 จว.ลุ่มเจ้าพระยารับมือ! เขื่อนเจ้าพระยาเพิ่มระบายน้ำ หลังน้ำเหนือหลาก ส่งผลท้ายเขื่อนสูงขึ้น
ฝนที่ตกทางพื้นที่ภาคเหนือตอนล่างและภาคกลางตอนบน ในช่วงสัปดาห์ที่ผ่านมา ทำให้มีปริมาณน้ำไหลลงลุ่มเจ้าพระยาเพิ่มขึ้นต่อเนื่อง
กรมควบคุมมลพิษ นัดแถลงผลพิจารณาเอกสารงานวิจัย กกร. สำรวจความโปร่งใส 25 พ.ค.นี้
กรมควบคุมมลพิษ นัดสื่อแถลงข่าว ผลการพิจารณาเอกสารงานวิจัย กกร. ผลสำรวจความโปร่งใสภาครัฐ 25 พ.ค.นี้
ปลัด ทส.สั่งทุกกรมแสกนหาภารกิจเสี่ยงทุจริต! ลั่นไม่ปกป้องคนผิด
ปลัด ก.ทรัพย์ฯ สั่งทุกกรมแสกนหาภารกิจเสี่ยงทุจริต หลังเรียกบิ๊กข้าราชการถกผลโพล กกร.เมื่อวาน เดินหน้าอุดรูรั่ว วางมาตรฐาน SOP ลดความกังวลใจ ลั่นไม่ปกป้องคนผิด
เปิด 4 คำถามควันหลง 'กกร. และเพื่อนไม่ทน' แถลงผลสำรวจ 10 สินบนหน่วยงานรัฐ
ดร.มานะ นิมิตรมงคล ประธานองค์กรต่อต้านคอร์รัปชัน (ประเทศไทย) โพสต์ช้อความผ่านเฟซบุ๊ก ว่า 4 คำถามควันหลง หลังจาก “กกร. และเพื่อนไม่ทน” แถลงผลสำรวจความเห็นของภาคเอกชนเรื่อง 10 สินบนหน่วยงานรัฐ ที่ไหนจ่ายหนัก ที่ไหนจ่ายบ่อย

